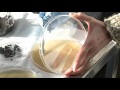

The project
Fighting pollution, plant diseases and soil impoverishment are some of the greatest challenges of the 21st century.
To contribute in addressing these major problems, new solutions with low environmental and economic impact must be provided.
The aim of this project is to contribute in developing these solutions by means of special microscopic fungi, selected for their great potentiality in bioremediation of polluted soil, in organic farms, and in agricultural soil biofertilization.
The Laboratory of Mycology has a long and proven experience in the study of fungi since the end of the 18th century, with a special focus on the possible applications of fungi in the field of environmental health.
The fungi we have discovered over the years are various and have given us great satisfaction, confirming that they are real “superheroes”. In fact, they are able to carry out many activities at the same time, such as: fighting plant pathogens, enhancing plant growth, fertilizing soil and remediating polluted soil. This is the reason why we like to call them ECOSMART FUNGI.
They produce enzymes with a high application potential. Chitinases, for example, are enzymes involved in the degradation of chitin and are used to combat plants’ pathogens; thanks to these enzymes many of the fungal species could be used for biological pest control in organic farming.
With the project “THE BUDDY FUNGUS”, we want to create and maintain a collection of the best ECOSMART FUNGI and make them available for biofertilization, bioremediation and biocontrol of plant pathogens for ecofriendly agriculture, in order to produce healthier food in a more sustainable environment. In fact, they represent green solutions at a low cost.
Thanks to your contribution, young postgraduates with a passion for scientific research would be able to work with us to create a formulated product based on active fungi that everybody can benefit from in their own gardens and plant pots of their terraces. With this ecological product, people can protect their plants and enhance the natural defense of the soil and contribute this way in improving the environment they live in.
LINK
http://www.fao.org/ag/save-and-Grow/en/3/index.html
http://www-3.unipv.it/det/micologia/indexmicol.html
Goals
The project has two goals of growing impact:
Primary Target: 10,000 €
allocated to organize and to enhance the collection with new ECOSMART FUNGI
The amount is divided as follows:
- Scientific equipment: 2,000 €
- Scholarship for a young assistant: 8,000 €
Secondary Target: 20,000 €
allocated to develop a starter kit containing the formulated product and the handbook.
Video
Media Gallery
Rewards
DONATION € 15,00
Amico Fungo pin logo
DONATION € 50,00
Logo T-shirt and, if the second target of 20.000 euro will be reached, you will receive the Research Kit (It is a box that contains the formulation, a handbook, and a working table where you can entry data on your plants. You will share a research experience with us and you will contribute in the development of the formulation prototype.)
DONATION € 500,00
The name of the donor will be acknowledged in the papers on the topic published on scientific journals
Team
Solveig Tosi
Prof. | FounderSolveig Tosi
Prof. | FounderAnna Maria Picco
Prof.Anna Maria Picco
Prof.Marinella Rodolfi
Dott.Marinella Rodolfi
Dott.Francesca Brescia
Dott.Francesca Brescia
Dott.Rino Cella
Prof.Rino Cella
Prof.Matteo Faè
Dott.Matteo Faè
Dott.Backers
-
Augusto Pirola Pirola
-
Anonymous
-
Anonymous
-
Anonymous
-
Francesco Sassone Pirola
-
EVERGREENBIOS SRL Pirola
-
Anonymous
-
dalla giornata dedicata ai legumi organizzato dal Sistema Bibliotecario di Ateneo
-
elisa lagostina
-
Matteo Di Domenica
-
Analytical Snc Pirola
-
Evento Motonautica di Pavia organizzato dal Sistema Bibliotecario di Ateneo
-
Sergio Tosi Pirola
-
Sara Martimucci
-
ATS MOOD Milano American Tribal Style Company
-
Andrea Bianchi
-
Analytical Snc Pirola
-
Alice Locatelli
-
Callovini Giovanna Di Alesio D
-
Marchionne Arianna Katia Marchi
-
Conti Giulia Pirola
-
Vittorio
-
Flavia Rocco
-
Anonymous
-
Farmacia Fapa di Marco Branca Pirola
-
Lidia Pucciarelli Pirola
-
LIdia Nicola
-
Flavio Pialorsi
-
Chiozzotto Vera Pirola
-
Selva Enrico Raguzzi Bianca
-
Anonymous
-
Claudio
-
Guido Barbato
-
Branca Marco Gazel Marie Domi
-
La Calvenzana di Cantù Stefano
-
Giuseppe Del Frate
-
Valerio Tosi Pirola
-
Anonymous
-
Marisa Punzi